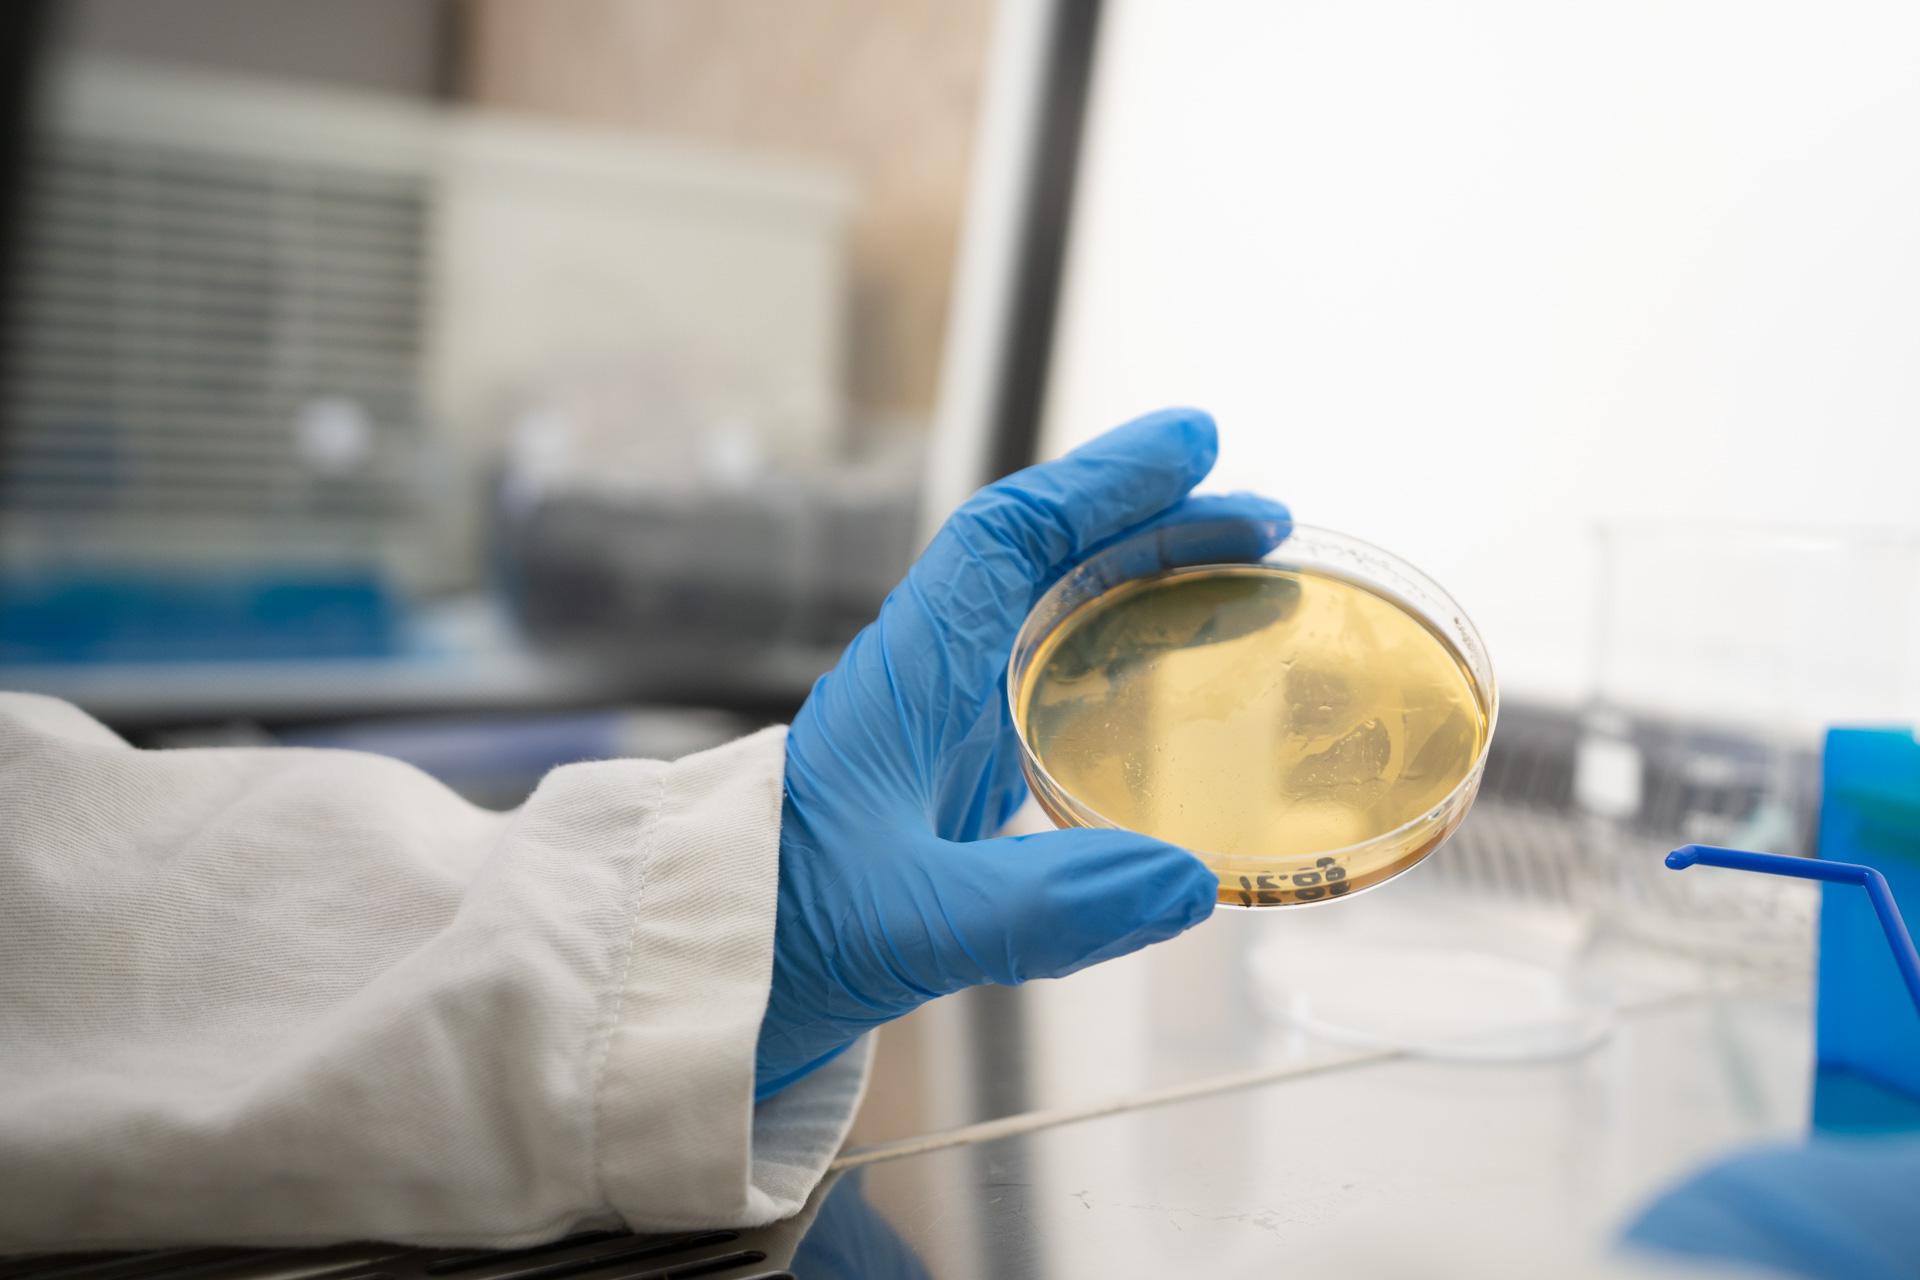
Vue-Bactéries
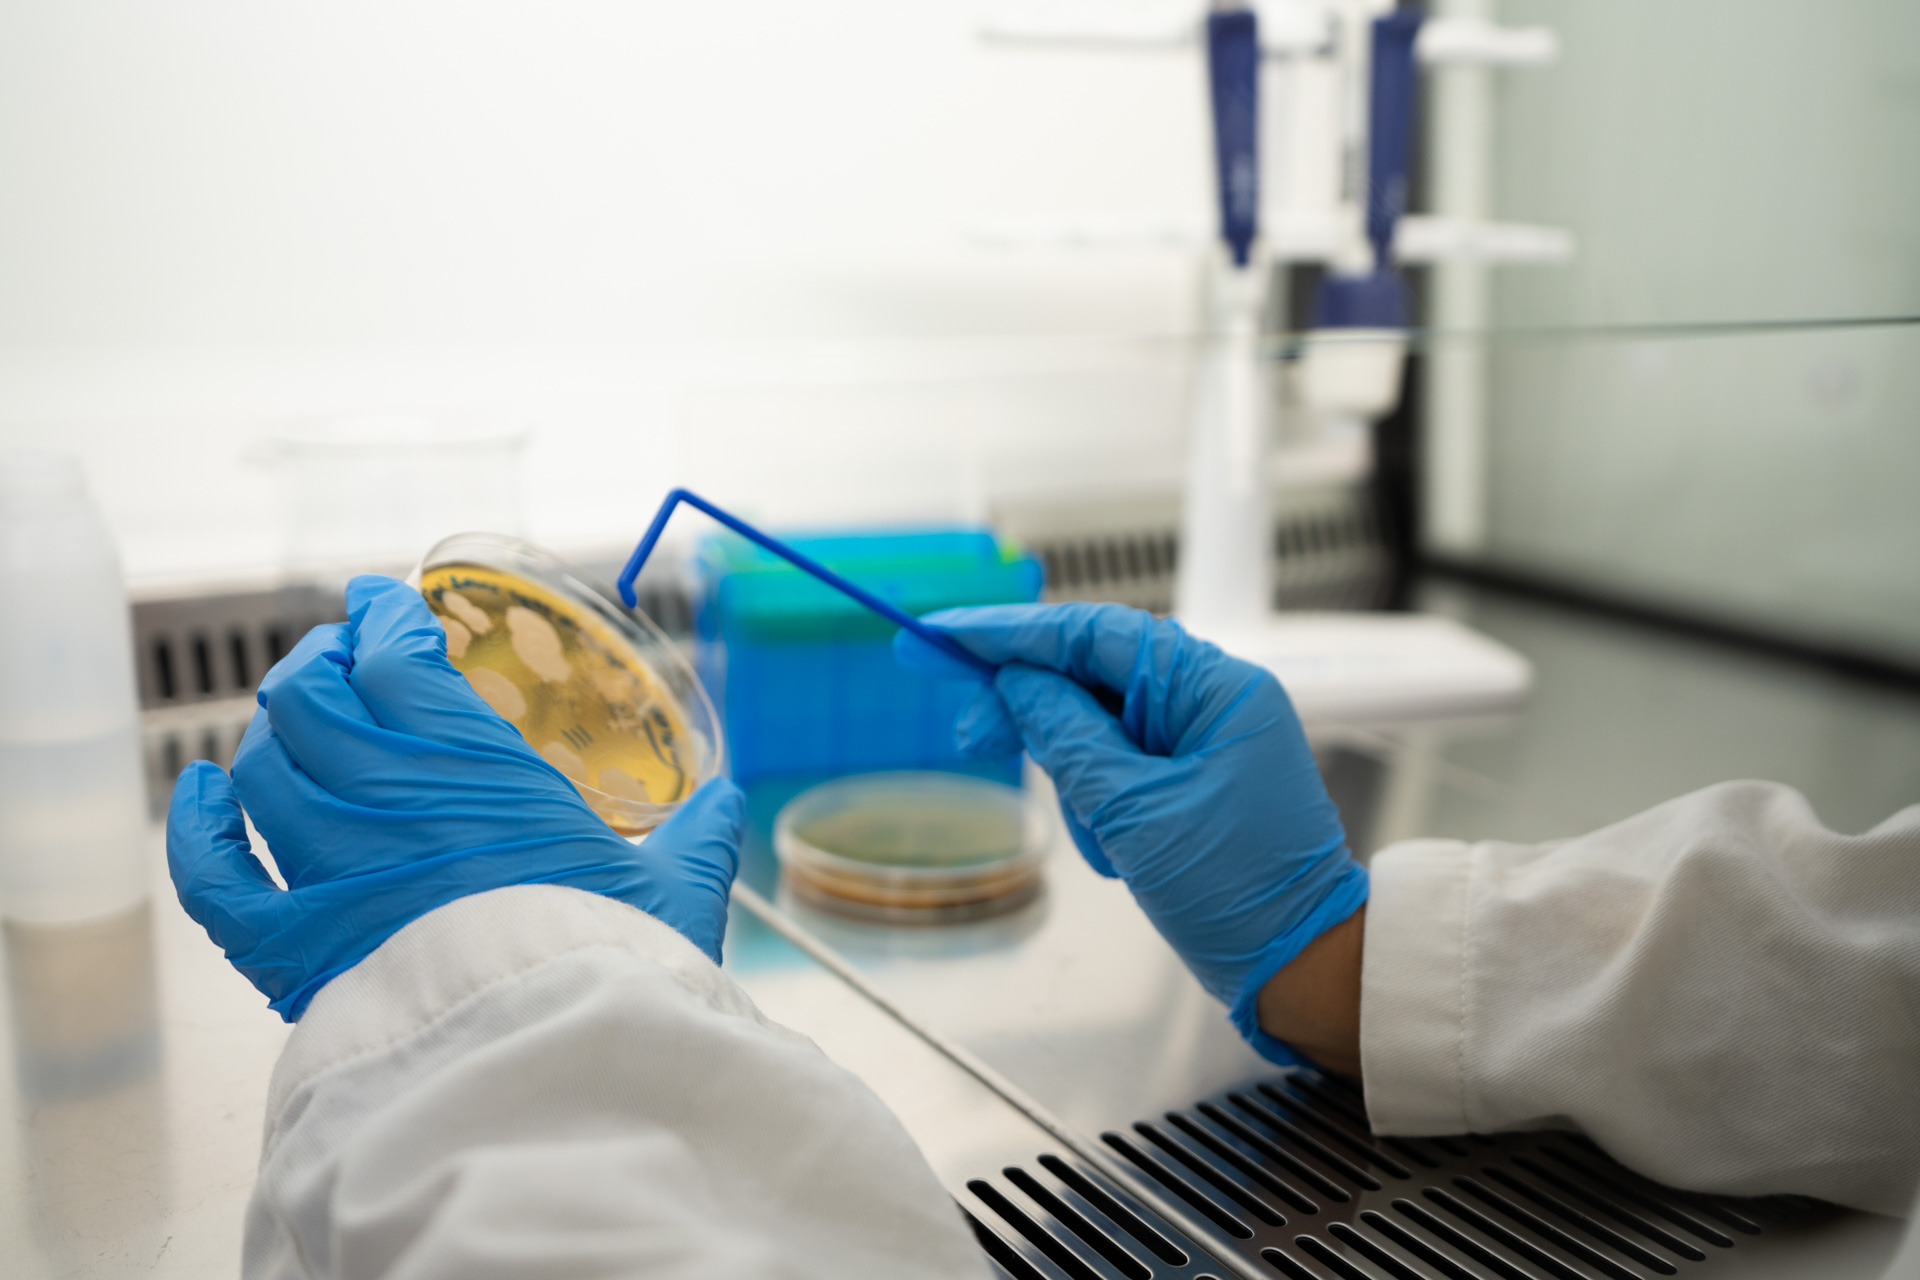
bactéries-Urine

TOOPI ORGANICS – Transformer l’urine en ressource

Description
La société TOOPI Organics a développé un procédé biotechnologique breveté permettant de recycler l’urine humaine en produits pour l’agriculture et l’industrie. Le processus TOOPI est basé sur l’utilisation de l’urine humaine comme support de culture pour des micro-organismes d’intérêt agronomique.
TOOPI propose la collecte de l’urine humaine dans sur les chantiers, dans les nouveaux bâtiments, les écoles, les collèges et lycées etc… pour ainsi la valoriser.
Le premier produit TOOPI a montré une efficacité agronomique similaire aux engrais de synthèse, tout en assurant une viabilité économique pour les agriculteurs. Le projet TOOPI est de créer une filière de recyclage, notamment basée sur un nouveau modèle d’économie circulaire territorialisée autour d’une matière première encore inexploitée : l’urine humaine.
Avis
Il n’y a pas encore d’avis.
Les avis sont fermés.
